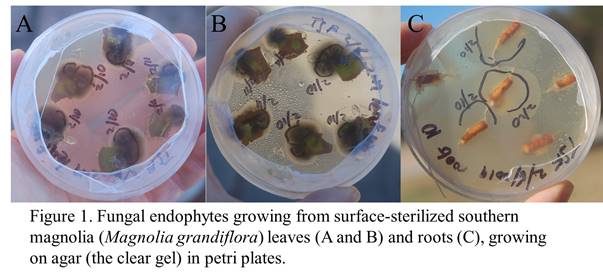

Critter of the Week NC
The following is a series called “Critter of the Week,” dedicated to the 1000s of species living on St. Andrews University campus. –Tracy S. Feldman, Associate Professor of Biology
Posts are regularly updated here: https://www.facebook.com/Tracy.S.Feldman.COTW
Critter of the Week Installment 1, 2 April 2021
Did you know we have tigers on campus? Well, maybe not tigers exactly--these tigers are actually beetles less than 1 inch long. They are called tiger beetles because they run along the ground to catch the prey insects they eat. Although their eyesight is great, they run so quickly that their eyes can't adjust to the movement, so they hold their antennae out in front of them to keep from running into things (https://www.sciencedaily.com/releases/2014/02/140211113704.htm). The species in the photo is called the oblique-lined tiger beetle (Cicindela tranquebarica), and it's one I hadn't seen on campus until a week ago. I got a decent photo this week, of a mating pair--males (on top) guard mates to prevent her from mating with other males (https://entomology.unl.edu/tigerbeetle/tiger_biology.htm#:~:text=To%20prevent%20immediate%20re%2Dmating,mating%20to%20discourage%20other%20suitors.). Larvae spend their time in deep burrows in the soil, like the sarlacc in Star Wars, eating any prey that happens to fall in. Many species tend to like sandy soils, hanging out on open sandy soil, on stream/river banks, or ocean beaches. If you encounter them, they will stop running and fly away from you, then will often land facing you--so it is hard to sneak up on them.
References:
https://www.sciencedaily.com/releases/2014/02/140211113704.htm

Critter of the Week Installment 2, 9 April 2021
Roses are red, violets are blue,
except if they’re yellow or green or white…
If this plant can’t find love, it won’t stew
it’ll make its own seeds by itself tonight!
Viola lanceolata, called Bog white violet or lance-leaved violet, is one of two species of white violets found on or near campus, and it is blooming now. This species is found in wet places. On our campus, it is found only in a strange wetland called the Carolina Bay. Carolina Bays (named for the bay trees that grow in some of them) are clay-lined oval-shaped depressions in the ground that fill with rainwater for at least part of each year. They are rare habitats, because many have been developed, drained, cut, or destroyed through other human activities like herbicides or mudding. Our Carolina Bay has many amazing critters in it, including some rare plants found in only a few places in the state. This violet is not rare, but it does have some interesting habits. For one thing, it makes two kinds of flowers—one that blooms out in the open (shown in the photos below), and another that has no petals and blooms close to the ground. Why would a plant do that? It turns out, it’s for insurance. Pollinators are often unreliable, so if pollinators are not around, any way that ensures seed production is beneficial to the plants. The regular flowers even have purple stripes called “nectar guides”, guiding pollinators to the place with the nectar reward (and the pollen), but even that does not guarantee pollinators will visit. So the tiny green flowers at the base of the plants fertilize themselves and then make seeds—no need for pesky bees or other plants. Who needs them? I guess you could say this violet is good at social distancing?
Sources: https://plants.ces.ncsu.edu/plants/viola-lanceolata/
https://treasurecoastnatives.wordpress.com/tag/blue-maidencane/

Critter of the Week Installment 3, 16 April 2021
Dedicated to the thousands of non-human neighbors who share our campus with us.
Could you imagine, in an average 79-year human lifespan, if you had only 2 years of childhood, followed by 75 years of sleeping (95% of your life), followed by 2 years of adulthood? No? This week’s critter of the week does that kind of thing, but all in one year—It is a tiny fly that starts out as an egg near the tip of a Japanese Wisteria (Wisteria floribunda) leaf. Once it hatches, it burrows into the leaf, feeding inside it—as if the top surface of the leaf was the ceiling and the bottom was the floor of a house, and it eats its way through the “rooms”—this is called leaf mining. It takes less than two weeks to eat and grow (the mine gets wider as it grows), then it gets ready go into the next phase of its life, the puparium (like a chrysalis), in which it slowly transforms into an adult. Once it pupates, it mostly sits there in the leaf litter for almost a year. Then the following March-April, the adult emerges and has only a little time to mate and lay eggs--kind of a grind of an existence. This fly is also a bit of a mystery. It is only known to eat Japanese Wisteria, but no one has found it in Japan. In fact, so far, the only place it has ever been found is here on the St. Andrews campus. It is quite probably a new species—we’ll find out hopefully within the year for sure—it was discovered here. Because of its weird life cycle, and because it is not so common, it has taken a while (5 years) to raise an adult successfully. So what did it eat before Japanese Wisteria was introduced from Japan? Many plant-eating insects are pretty picky eaters, because different plants have different poisons. It does not seem to feed on the native Wisteria growing on campus. Did it come from Japan? The plant this fly eats is all over the place here—Japanese Wisteria is an invasive species, meaning that it takes over places where it grows and grows out of control, keeping native plants around it from growing successfully. Japanese Wisteria has been introduced throughout the eastern US, and its leaves are available from April to October—so is this fly really only found here? Why is it active only in early spring, for such a short time? Perhaps I’ll be able to let you know in a future installment… for now, time to get some sleep!

Critter of the Week Installment 4, 23 April 2021
Dedicated to the thousands of non-human neighbors who share our campus with us. Brought to you by Science at St. Andrews and two students from my Biology 101 class.
Today’s critter of the week is actually about three critters and three small themes. First the critters: three different species of moths (see below). Although people often think butterflies fly during the day and moths fly during the night, there are lots of exceptions. Many moth species (like the ones below) fly during the day, and a few butterfly species (like the cave skipper in Central America) fly at night*. If you look at the ones in the photos closely, you’ll see they all look a little bit like bees, with yellowish contrasting with dark brown or black—those could be “warning colors,” which either advertise poisons within (so predators stay away) or mimic other critters that have those poisons (again, so predators stay away). There are many such mimics out there—a theme I will revisit. None of these three bee-mimic moth species had been documented on campus before (and more could be out there). All were seen feeding on azalea nectar that was extremely abundant here this past week. Which brings me to my next themes…
These moths are here because their food is here—a deceptively simple statement. In the photos, it looks like all they need is a few hundred azalea flowers to be happy. Yet these insects live a “double life”—their earlier life stages are caterpillars that chew on leaves of plants—totally different from the adults that suck nectar through straw-like mouths. And caterpillars are picky about what they eat. Thus, their host plants (plants caterpillars eat) must be here too—plants like blueberries (Vaccinium fuscatum and other species) for the hummingbird (or slender) clearwing, native honeysuckle (Lonicera sempervirens) for the snowberry clearwing, and Grapes (Vitis sp.), Peppervine (Ampelopsis areborea), and Virginia creeper (Parthenocissus quinquefolia) for the Nessus sphinx. Maintaining diverse plants here will support a large diversity of organisms that depend on them (theme 2).
Also (theme 3), the science of biodiversity depends on scientists and non-scientists alike, looking around and documenting what they see. It takes a village to figure out how many species we’ve got out there. In this case, Biology 101 students, including Matthew Williamson and Ivo Sperone, saw insects visiting azalea flowers and started taking photos. The result was that all together, we documented at least 8 species of bees, moths, and butterflies visiting azalea flowers.
If you want to document biodiversity too, iNaturalist (https://www.inaturalist.org/users/sign_in) is the perfect app to do it—all you need is a decent photo (cropped so the organism shows well), along with where and when you saw it. You can help document biodiversity here and elsewhere.

*If you want to tell a butterfly from a moth, look at their antennae—butterflies have bulbs at the end of their antennae, and moths do not.
Sources: https://auth1.dpr.ncparks.gov/moths/index.php
Critter of the Week Installment 5, 30 April 2021
In this episode, we face carnivorous plants… The lake is full of carnivorous plants ready to swallow you whole… but only if you are about as small or smaller than the head of a pin… So you are safe--you can breathe a sigh of relief as you go for a swim in the lake…
Why would plants be carnivorous? You might notice in the close-up of the leaves below that the leaves are green. That means they conduct photosynthesis, the process of capturing light energy and using that energy to build sugars from carbon dioxide in the air (yes, plants are made of thin air!). If they make their own food, why would they need to be carnivores? The answer is that plants need more than sugar. This might not be a surprise—you would not do well if you lived only on sugar, as tempting as it may be for those of us with a sweet tooth. Plants are like us in that they also need nutrients like nitrogen (common in proteins we eat) and phosphorus, to function. In fact, the green stuff that helps capture energy from light (chlorophyll) is partly built out of nitrogen. Unfortunately, nitrogen is often hard to get—and when it is particularly hard to get, plants that end up with ways of getting more nitrogen do better than those that suffer with less. One way of getting more nitrogen is to team up with fungi (for a later post). Another way is to trap animals and get protein from their bodies.
Different groups of carnivorous plants have different ways of trapping insects. The carnivore pictured below is Utricularia inflata, or the inflated bladderwort. “Wort” means “plant”—so it is the bladder plant. There are two species of bladderwort on campus—one that blooms in spring and one that blooms in fall—those are the only carnivorous plant species on campus, although the Southeastern Coastal plain is the most diverse place in the world for carnivorous plant groups—even the Venus Fly Trap is found only in North and South Carolina. So what do these carnivores trap, and how do they trap them? The little bladders on the bladderwort’s leaves are bubbles of air under water, with doors that open inward. When a tiny crustacean (crab and lobster relatives) like water fleas swim by and trigger the door, the door opens inward. The tiny animal is swept into the bladder with the rush of water that enters, and the door closes—because the door only opens inward, the animal is trapped, and later digested. Now you can be amazed—or terrified—as you gaze at the beautiful, feathery, deadly underwater leaves of the bladderwort growing on the edges of our lake.

Source: https://www.sciencedaily.com/releases/2016/01/160129134331.htm
Critter of the Week Installment 6, 7 May 2021
I hate goodbyes… this is a time for goodbyes, to graduates and to others (for the summer at least)… During these past few weeks, a related event is occurring in the bird world. A river of birds has been passing through—a river of migrants moving north, seeking less competition for food than they had in the Caribbean or in the tropics, and seeking open breeding grounds. Some birds also overwinter here. Many birds (like white-throated sparrows and slate-colored juncos) that have been with us since the fall are taking their leave and moving back up to the northern US or Canada. Many of those will be gone from campus in a few weeks, if they haven’t gone already. Of the 153 bird species recorded from campus, at least 83 of those migrate (they are winter or summer residents)—at least 23 were just passing through on their way to somewhere else.
Some of the most spectacularly colored migrants are the wood warblers. They migrate on clear nights, finding their way by the stars. Other birds use the sun as a compass, or landmarks, or even the Earth’s magnetic field. To detect the magnetic field they must have magnetized materials in their bodies or charged chemicals that can respond to the magnetic field.
But our migrants are threatened. Migrants can be threatened in more ways than residents—residents can lose their homes, but migrants can lose their breeding grounds OR their overwintering grounds OR important stopovers. Habitat losses are one big reason for these threats. Another reason is pesticides—we are pouring poisons into our environment on homes, yards, and crops. This means our insects are disappearing, which means less food for birds. Another is herbicides—getting rid of plants that give cover for birds (protection from predators), or that serve as food for the insects they eat. Climate change may be another reason, as birds are migrating at different times (earlier), and may sometimes migrate too early or too late to intersect with food sources they depend upon to fuel their journey or to feed their babies on nesting grounds. Another is urbanization—buildings account for many bird deaths, as they see reflections of sky in them and ram into them at high speed (see below). In 1962, Rachel Carson wrote “Silent Spring”, warning us that we would lose our birds if we continued using some pesticides. Some like DDT were banned in the US soon after. Yet birds are still in decline, and studies suggest that in North America we have lost 30% of our birds since 1970.
The positive side is that when we see migrants, we can appreciate that they’ve survived a lot to get here—hundreds of miles, exhaustion, obstacles, predators—and a trip that is harder than it used to be. Another possible positive side is that many of the threats to migrants are things we humans can do something about—if only we could see the value in our non-human neighbors… On campus in late April this year, I heard or saw only 7 warbler species—in past years I have seen or heard 10 or 11 species. I hope this year is just a fluke.
I do hate goodbyes… (I could say the photos below are blurred with sentimental tears…but in reality I just don’t have the photographic equipment for good bird photography unless the bird is dead or right in front of me—forgive the blurs that are supposed to be birds). At this season, all I can do is hope that graduates stay in touch, and come back through periodically… All I can do is hope we humans change the practices that are making our birds and many other living things go extinct… that I can still continue to say “see you next year.”

https://earther.gizmodo.com/north-america-has-lost-30-percent-of-its-birds-since-19-1838251286
https://www.audubon.org/news/how-scientists-learned-about-blackpoll-warblers-epic-migration
Critter of the Week installment 7 (2 September 2021)
Sharpshooters suck—it’s not what you think…
It’s the start of another semester, so I am re-starting the “critter of the week” posts, devoted to the thousands of non-human neighbors that share St. Andrews Campus with us. I am also co-teaching a course that deals with symbiosis, so I’ll try tying my posts this semester to the theme of symbiosis.
This post starts with a critter that sucks—literally. Imagine if you could take in food only through a straw. These critters, called glassy-winged sharpshooters (Homalodisca vitripennis), have mouth parts that look like straws—they are good at inserting these mouthparts into plants and sucking plant juices out (other relatives, called assassin bugs, pierce insects and other animals, sucking them dry). They occur on various plants on campus, and are out now. Their dramatic name may come from the damage they do to plants (the holes caused by their mouthparts), from their tendency to hide behind plant stems when disturbed, or from their ability to forcefully shoot streams of liquid away from them (https://entnemdept.ufl.edu/creatures/fruit/sharpshooters/sharpshooters.htm). Yet this only scratches the surface of why they are interesting…
Imagine being on a liquid diet. You’d have to drink a lot to get nutrients you need (ok, there are concentrated nutrient drinks out there, but still…). This also means you’d have to urinate a lot—A LOT… And, if you are like these sharpshooters, it’s kind of like sticking your mouth into a water pipe—there’s a real danger of imbibing too much liquid, and, well, exploding! This is something few college students know anything about, fortunately…
A few adaptations help them deal with this feeding method. First, their digestive system is horseshoe shaped, and liquid can move from the head-end of the digestive tract (the foregut) “directly” to the tail-end (the hind-gut) without having to pass through the whole digestive system (e.g., Dai et al. 2009). This means they can get rid of extra fluid quickly—in their case, they shoot it out—thus, the rapid ejection of fluids for which these insects are named. Second, they don’t get much protein on a liquid diet (they have no cans of sport drinks or high-protein shakes to suck on)—but they do have bacteria! The sharpshooters have specialized pockets in their bodies that house bacteria called Sulcia and Baumannia (only recently discovered—see Moran et al. 2005). These bacteria make 10 different amino acids for them, and the insects can build the proteins they need from these amino acids, and what they get from the sap they eat. The bacteria live on the insects, and are passed on to eggs by mother insects, so their babies have them too. The bacteria have lost some genetic material over time, so they can no longer function on their own, independently of the sharpshooters. This close association between different organisms (in this case, at least 3 different ones) is called “symbiosis”, or “living together”. There are many examples on campus, and I will highlight some organisms involved in symbioses over the course of this year.
Meanwhile, I hope I have convinced you that the sharpshooters, although they suck, do not suck so badly!

Sources:
Bennett G.M. and Chong R.A. 2017. Genome-Wide Transcriptional Dynamics in the Companion Bacterial Symbionts of the Glassy-Winged Sharpshooter (Cicadellidae: Homalodisca vitripennis) Reveal Differential Gene Expression in Bacteria Occupying Multiple Host Organs. Genes, Genomes, Genetics 7(9): 3073-3082.
Dai L., Yang B., Wang J. Zhang Z., Yang R., Zhang T., Ren Z. and Lin C. 2009. The Anatomy and Ultrastructure of the Digestive Tract and Salivary Glands of Hishimonus lamellatus (Hemiptera: Cicadellidae) Journal of Insect Science 19(4): 3; 1–9.
Moran N.A., Tran P., and Gerardo N.M. 2005. Symbiosis and Insect Diversification: an Ancient Symbiont of Sap-Feeding Insects from the Bacterial Phylum Bacteroidetes. Applied and Environmental Micobiology. p. 8802–8810
https://entnemdept.ufl.edu/creatures/fruit/sharpshooters/sharpshooters.htm
Critter of the Week installment 8 (10 September 2021)
It makes a village…
This week touches on the theme of symbiosis, but then broadens out to a whole community—an entourage, if you will. Imagine a nice cool clear mountain spring, and a whole amazing community of plants and animals that grow around the spring and depend upon those water resources. Now imagine that it’s a spring made of sugary-tasting poop instead… ok, maybe I’d better start at the beginning.
This community is centered around a symbiosis: Tag alder trees (Alnus serrulata) grow by the lake, and their roots are colonized by a group of bacteria called Frankia. These bacteria can do something amazing—they can take nitrogen gas, which for most organisms is inert (we cannot use it directly for anything) and change the nitrogen into a form that plants can use—nitrogen is often hard to come by, so that it’s handy for Alders to have their own built-in nitrogen factories. And, these alders are colonized by woolly alder aphids (who, by the way, need nitrogen too)…
Remember the sharp-shooters in the last posting? They imbibe sugary plant sap through a straw-like mouth, and have to release a good bit of that water so they do not explode. Many relatives of sharp-shooters do the same thing, putting out sugary exudates, or poop as they feed. The woolly alder aphids (Prociphilus tessellatus) do not shoot the exudates—instead, the exudates just dribble out (where’s the fun in that?). The aphids are more likely to colonize alders with Frankia than alders without Frankia (Hendrickson et al. 1993). Remember the bacterial symbionts of the sharp-shooters that provide the building blocks of proteins (which have nitrogen)?—in the case of the alders and the aphids, it is like symbiosis once removed—they are benefitting from the nitrogen the alders are getting from Frankia.
Once the poop dribbles out (like a cool clear mountain spring?), other critters take notice. Ants come and tend to colonies of the woolly aphids, protecting their “herd” of aphids from predators, while harvesting the exudates (poop) they eat (ants milking their “cows”?). And the exudates that dribble onto the leaves below also host a variety of creatures, from a specialized fungus (Scorias spongiosa—the name and its look evokes a dirty kitchen sponge) that grows on the exudates to bees and wasps that scavenge the sugary poop off of the leaves (see Figure 1).
There is also a predatory caterpillar that eats the aphids… let me back up… a predatory caterpillar, yes you heard that right. Normally caterpillars are vegetarians, eating leaves off of plants while they scream in agony. Yet these predatory caterpillars plow through woolly aphid colonies while the aphids scream in agony… Predators are often vegetarians once removed, after all? The fall is the best time to see the aphids on the alders, and a few years ago I saw a couple of harvester caterpillars, as these predators are called. I collected the pupa, and kept it in the refrigerator all winter. In the spring I took it out and sat it on my desk. In a couple of weeks, a harvester butterfly emerged, which I released by the lake (see Figure 2)…
So you could say that the Frankia/alder symbiosis encourages this whole system to operate, with its aphids, ants, wasps, bees, fungi, and predatory caterpillars, all under our noses along the lake shore…


References:
Hendrickson O.Q., Burgess D., Perinet P., Tremblay F., and Chatatpaul L. 1992 Effects of Frankia on field performance of Alnus clones and seedlings, Plant and Soil 150: 295-302, 1993.
Reynolds H.T. and Volk T. 2007. Scorias spongiosa, the beech aphid poop-eater, Tom Volk's Fungus of the Month for September 2007; https://botit.botany.wisc.edu/toms_fungi/sep2007.html
Critter of the week Installment 9 9-17-2021
Living on the edge…
Imagine you were able to “deactivate” during hard times, then “reactivate” and continue when times get better… Crazy huh? If we could do that, some of us might even deactivate now! Imagine you could live on sunlight and air, living where almost no other critters can live—including bare rocks…
If you look on many of the tree trunks and branches (or some rocks, or occasionally on the ground) on campus, you might see greenish-gray or yellowish crust—often peeling and ruffled on the edges. These are called lichens (see the picture below, showing lichens from campus). They may not look like much (torn-up pieces of your last homework assignment?), but they are really amazing.
First, they are actually a team of organisms—a symbiosis. Symbiosis literally means “life together”--two or more living things that live in close association for most of their lives. The first living things described this way (in 1876) were lichens. Lichens are a partnership between several organisms. The critter that largely determines the shape of the lichen is a fungus—fungi is a large group (a kingdom) of organisms known for making mushrooms (and often molds). The main lichen fungi are related distantly to baker’s yeast and the much-sought-after morels. The other partner might be green algae (related to plants) or cyanobacteria (related to bacteria), or both. Both green algae and cyanobacteria can do photosynthesis, capturing energy from the sun and using that energy, along with carbon dioxide from the air, to make sugars. Fungi cannot make their own food, but if they partner with algae or cyanobacteria, they have their own internal food factories. In exchange, the fungus produces a array of chemicals, some of which block harmful sun rays, keep away insects or other critters that would eat the lichens, keep competing lichens away, and break up the stuff they grow on so they can get a “foothold” and stay in place (Rundel 1978). Some chemicals are antioxidants, some that protect the lichens from bacteria or viruses (Goga et al. 2020). Sometimes, the lichen is made up of three partners—the fungus teams up with both a green alga that photosynthesizes and a cyanobacterium that takes nitrogen from the air and makes it available for use by all partners (like Frankia does for Alders in the last post). Many of the fungi in lichens cannot survive without their algal or cyanobacterial partners.
Second, many lichens live on tree bark, fence posts, bare rocks, or even plastic playground equipment—places where water is not easy to get (living on the edge). Many lichens can dry out during a drought, then when rains come, they can rehydrate and resume their regular activities… A few other organisms can do that kind of thing (mosses, some ferns, some clubmosses, and a few animals like rotifers and some shrimp), but not many. Also, they are not parasites, and do not harm the trees on which they grow—they get nutrients from dust particles in the air. Some lichens can break rocks—some chemicals help them insert part of the fungus in the rock, then the fungus expands when it is wet, cracking the rock into soil that plants can grow in—in some places, lichens were/are the first step in making soils from rocks (Laubach 2018). So we can thank lichens for helping to make at least some of our fertile soils—we humans depend on this symbiosis too.
There are at least 3600 lichen species in North America (About Lichens), and I have no idea how many of those live on St. Andrews campus (wide open area for a future research project!). Photos of a few lichens from campus are below. There’s more to say about lichens, but I’ll do that in my next post, “Worlds upon worlds”…

References:
Goga M., Elečko J., Marcinčinová M., Ručová D., Bačkorová M., and Bačkor M., 2020. Lichen metabolites: an overview of some secondary metabolites and their biological potential.
Laubach E. 2018. Lichens: the story of a soil maker https://appvoices.org/2018/12/18/lichen-the-story-of-a-soil-maker/
Rundel PW 1978. The ecological role of secondary lichen substances. Biochemical Systematics and Ecology 6:157-170.
https://www.fs.fed.us/wildflowers/beauty/lichens/about.shtml
Critter of the week Installment 10 9-24-2021
Worlds upon worlds…
When I left off last week, I was talking about lichens, and how amazing they are. I am perpetually amazed by small worlds akin to Whoville in Dr. Seuss’s classic “Horton Hears a Who”… This kind of world (although perhaps not with buildings, horns, and yoyos) might be right under our noses, especially if we have walked face-first into the trunk of a tree…
As I discussed last time, lichens are a partnership of two or three species: the lichen fungus, the green alga and/or bacterial (cyanobacteria) partner—the fungus potentially provides nutrients and protection while the algal partners provide sugars from photosynthesis, and maybe nitrogen from the air changed into a useful form. Yet lichens are even more of a team than this. Over the past couple of decades, researchers have uncovered large communities (many species) of organisms living on lichens. These communities include additional fungi, additional algae, bacteria, protists, and viruses, in addition to animals.
The “lichenicolous” fungi are fungi that grow as parasites on lichens. Over 2,000 species of these fungi are now known to science, and most of these may grow only on lichens (Diederich et al. 2018). I don’t know if any of these fungi occur on campus, but I have started to look for them. I imagine there must be some—in fact, I suspect that two of the photos below may show lichenicolous fungi... Either way, it is an area that requires more observations and research.
The algal and bacterial communities on lichens have been discovered only recently by collecting lichens and sampling the DNA on and in those lichens—whenever scientists look for DNA sequences that are specific to bacteria and algae, they find evidence of many different types (for example, Smith et al. 2020). I know, bacteria in particular are everywhere—on virtually every surface that has not been disinfected recently (and many that have been disinfected). But the bacterial communities on lichens seem to be distinct from the bacteria in the surrounding environment (Bates et al. 2011)—are bacteria specialized to lichens? Maybe. And what are they doing there? Much is still unknown.
There are even protists (of the sort you might find as single-celled organisms in a drop of pond water) and viruses found on lichens (Hawksworth and Grube 2020)—and these are likely to be different from types you’d find on other organisms. Of course, there are many larger animals that are known to eat lichens as well—there are many lichen-feeding mites (related to spiders—but mites are usually much tinier; Seyed 1984), moth caterpillars, as well as reindeer, and even red crabs (Lepp 2012)… Also, it is worth noting that anything that eats or grows on Lichens must be able to deal with the myriad strange chemicals inside.
This complex community of organisms living on and in lichens led famous biologists David Hawksworth and Martin Grube to claim that lichens should be redefined as complex ecosystems (Hawksworth and Grube 2020). Ecosystems are typically large areas. Even though lichens are tiny—the “who-ville” ecosystems—lichens also make up a sizeable chunk of the living matter of many habitats in nature. So lichens may well make a big contribution to biodiversity and biological processes on earth.

References:
Bates S.T., Cropsey G.W.G., Caporaso J.G., Knight R., Fierer N. 2011 Bacterial Communities Associated with the Lichen Symbiosis. Applied and Environmental Microbiology, February: 1309-1314.
Diederich P. Lawrey J.D., and Ertz D. 2018. The 2018 classification and checklist of lichenicolous fungi, with 2000 nonlichenized, obligately lichenicolous taxa. The Bryologist 121(3): 340-425.
Hawksworth D.L. and Grube M. 2020. Lichens redefined as complex ecosystems. New Phytologist 227: 1281-1283.
Lepp H. 2012. Lichens, vertebrates, and invertebrates. https://www.anbg.gov.au/lichen/ecology-vert-invert.html
Seyed E.L. 1984. The association of orobatid mites with lichens. Zoological Journal of the Linnean Society 80:369-420.
Smith H.B., Dal Grande F., Muggia L., Keuler R., Divakar P.K., Grewe F., Schmitt I., Lumbsch H.T., and Leavitt S.D. 2020. Metagenomic data reveal diverse fungal and algal communities associated with lichen symbiosis. Symbiosis 82:133-147.
Critter of the week Installment 11 10-1-2021
Sometimes I find interesting things at windows—not just the cool things I see outside the windows, but also organisms that are influenced by the windows themselves. Sometimes birds hit the windows of the buildings here and die (like earlier this week, when another warbler hit), or sometimes insects or other animals get into buildings and die before they escape… Sometimes biologists, scientists who study life, also study death…
Recently, I found something interesting on one of the windowsills in the LA building: a bright iridescent blue/green wasp, belonging to a crazy group of wasps called cuckoo wasps (see the figure below). They have brilliant colors (no one really knows why—perhaps a defense mechanism, if predators are confused by the reflecting light?) and a very interesting life style…
Many wasps make nests in little holes in the ground (many different solitary wasps), or in mud-walled chambers on the sides of buildings or rocks (the mud-dauber wasps and mason wasps, among others). They are predators, and many wasp species feed their babies on paralyzed prey (often spiders or moth caterpillars). They sting their victims to paralyze them, and stuff the immobilized prey into their nests along with their eggs. Then they seal off the chambers so their babies can feed on the fresh (paralyzed, not dead) food. Gruesome, right? It gets crazier…
All of this food is a great resource (even though I know we might not crave a mud-encrusted paralyzed spider plate), and parasites like the cuckoo wasp take advantage of it. They have a long ovipositor (an organ that places eggs—see the figure below), and insert it into the nests of wasps to lay their eggs. Their babies hatch out of the eggs, and eat the food meant for the wasp that made the nest, and then eat the nestling wasp too… This means the cuckoo wasp is a parasite of predators… They are even more extreme parasites than their namesakes, the cuckoo birds that lay eggs in other bird nests (nest parasite). Thus, they are called parasitoids, a special kind of parasite that kills its host. They also steal food from their victims, which also earns them the designation of kleptoparasite (Crew 2018; Lukas 2012).
Is this a symbiosis? First, symbiosis is a close association between two or more organisms, and that association can be mutualistic (both partners benefit) or parasitic. And they are living in close association with their victims (in wasp nests) for most of their lives… but it is a looser association than some other examples I’ve discussed in other posts. The adults are free to come and go, but they always come back to the nests of other wasps… But it is even better than that—to “sneak” into wasp nests without being detected, many species of cuckoo wasp use something called chemical mimicry (Polidori et al. 2020; Strohm et al. 2008). The wasps they parasitize have chemical “smells” so that they recognize other members of their species. Many cuckoo wasps smell/taste like their victim wasps, so they remain undetected even when sneaking into nests (or, if discovered, they curl up like the dead one in the photo below). One species of cuckoo wasp even lays its eggs inside its host’s prey, so the host wasp delivers a Trojan horse to its own nest (Winterhagen 2015)... This means that many cuckoo wasps are specialized to parasitize a single host type, increasing the “closeness” of the association between them and their victims.
Sometimes, a story comes out of a dead critter... Hopefully its memory will live on with all of you.


References:
Crew B. 2018. This beautiful wasp is a parasitic killer. https://www.australiangeographic.com.au/blogs/creatura-blog/2018/01/the-beautiful-cuckoo-wasp-is-a-parasitic-killer/
Lukas 2012. The Cuckoo Wasp: A Gorgeous Parasite. https://baynature.org/article/the-cuckoo-wasp-a-gorgeous-parasite/
Polidori C., Bellesteros Y., Wurdack M., Asis J.D., Tormos J., Baños-Picón, L., and Schmitt T. 2020. Low Host Specialization in the Cuckoo Wasp, Parnopes grandior, Weakens Chemical Mimicry but Does Not Lead to Local Adaption. Insects 11.
Strohm E., Kroiss J., Herzner G., LaurienKehnin C., Boland W., Schreier P., and Schmitt T. 2008. A cuckoo in wolves' clothing? Chemical mimicry in a specialized cuckoo wasp of the European beewolf (Hymenoptera, Chrysididae and Crabronidae). Frontiers in Zoology 5:2.
Winterhagen P. 2015. Strategy for sneaking into a host’s home: The cuckoo wasp Omalus biaccinctus (Hymenoptera: Chrysididae) inserts its eggs into living aphids that are the prey of its host. European Journal of Entomology 112(3):557-559.
Critter of the week Installment 12 10-8-2021
There are many natural history events that seem to occur swiftly, in the blink of an eye—if you aren’t watching on the right day, or even the right time of day, you might miss them. One of these events is the migration of birds called chimney swifts (Chaetura pelagica). These birds nest on cliffs, in addition to the buildings, air ducts, and the chimneys they are named for—but luckily they nest during the summer, so they are unlikely to get burned by fires in said chimneys… Sometimes you might see them congregate over the downtown areas in small towns, clicking their song as they wheel through the skies at 15-21 miles per hour, and sometimes up to 36 miles per hour (Schnell and Hellack 1978)—they are named “swifts” for this reason. Some sources argue that chimney swifts can travel up to 150 miles per hour, yet this may well be apocryphal (Aaron 1937)—other swift species have been clocked at 69 miles per hour (VanHelder 2016). They are built for speedy flight—very long thin wings, small body (looks almost bat-like), and a kind of stubby tail, perhaps for providing balance when they cling to cliff sides or sheer brick walls. I do not have a photo because they are too fast for me (!!) and usually stay higher up than my smaller camera lenses can reach—but you can see one here https://ebird.org/species/chiswi.
And they migrate, spending summers throughout the eastern US up to mid-Canada during nesting season, then crossing the Gulf of Mexico and spending their winters in South America as far south as Chile (https://ebird.org/species/chiswi). They nest on (or nearby) our campus. Last year, during one morning in the first days of October, I saw hundreds of them whirling and diving over Lake Ansley Moore. There aren’t typically hundreds of them on campus, so this was likely a stopover for the birds along their migration route, as they fuel up on the millions of mosquitoes and gnats that plague us during this time of year (they eat many other kinds of flying insects as well). I may well have missed the surge of migrants this year, but I hope not.
And “where is the symbiosis connection this week?”, you might ask. My answer: birds have lice… not just any lice. Most bird species are infected by lice that are different from the sucking lice that humans get—they are bird lice, members of a group of chewing lice called Phthiraptera (say that 10 times fast—or even one time…). They are ectoparasites (parasites on the outside of the bird’s body), and because these insects are wingless (that’s what “-aptera” means), they are often tied with their bird hosts—most are specific to one bird host species (Clayton et al. 2002). They do move around though, crawling from one bird to another at nest sites, or even hitching rides on biting flies, riding from bird to bird on their insect transports (Clayton et al. 2004). Their specificity has received the attention of many biologists who study symbioses (close associations between species), as there is some evidence that new species of lice have evolved with their bird hosts—so when two new bird species evolve from one ancestral bird species, the lice do the same thing, becoming two new species. In other words, the louse species on the newly diverged species of birds each diverge from each other, until the two groups of lice are also separate species, one on each of the two new bird species. There is evidence of this “co-speciation” between swifts (and other birds) and their bird lice (Clayton et al. 2004). Bird lice are so specific that scientists have used them to determine relationships between species of their bird hosts themselves (Cohen et al. 1997).
Just think—this crazy aerial ballet (with multiple subplots) is going on, far above our heads—and if we blink, we might miss it.
References:
Aaron S.F. 1937. Speed awing. Scientific American 157(5): 283-286.
About Chimney Swifts https://www.massaudubon.org/learn/nature-wildlife/birds/chimney-swifts/about-chimney-swifts#:~:text=The%20Chimney%20Swift%20(Chaetura%20pelagica,bees%2C%20wasps%2C%20and%20moths.
All about birds, Chimney Swift https://ebird.org/species/chiswi
Cohen B.L. Baker A.J., Blechschmidts K. Dittmann D.L., Furness R.W., Gerwin A.J., Helbig A.J., DeKorte J., Marshall H.D., Palma R.L., Peters H.U., Ramli R., Siebold I., Wilcox M.S., Wilson R.H., and Zink R.M. 1997. Enigmatic phylogeny of skuas (Aves: Stercorariidae). Proceedings of the Royal Society of London 264: 181-190.
Clayton D.H., Bush S.E., and Johnson K.P. 2004. Ecology of congruence: past meets present. Systematic Biology 53(1): 165-173.
Schnell G.D. and Hellack J.J. 1978. Fight speeds of brown pelicans, chimney swifts, and other birds. Bird banding 49(2):108-112.
VanHelder 2016. The common swift is no longer the fastest-flying animal.: And here's a surprise: It wasn't even dethroned by another bird. https://www.audubon.org/news/the-common-swift-no-longer-fastest-flying-animal Audubon news.., November
Critter of the week Installment 13 10-15-2021
The world-wide web…
We all rely on the internet these days—even when I write these “Critter of the Week” pieces, I use it to fact check, explore research, etc. The internet is an amazing human innovation. Yet forests have been using a kind of “internet” long before humans were around, perhaps starting from when organisms first crawled… or grew… out of the oceans.
Plants are great at converting energy from sunlight into chemical energy that all living things can use—they use that energy to build sugars from the air around them (carbon dioxide gas in the air, to be exact), then build their bodies with this converted air. They do this so well that there is often a surplus of sugar to go around. Yet the nutrients like nitrogen that they use as part of their sunlight-capturing mechanism (chlorophyll, etc.), is much harder to come by. Fungi, on the other hand, cannot photosynthesize to save their lives. Soil fungi have thread-like bodies that are great at finding nutrients—much better than plants are. Hundreds of species of fungi associate with plant roots, taking sugars from the plants and providing nitrogen, phosphorus, and water in return. These root-associated fungi are called mycorrhizae or “fungus roots.” Not all mycorrhizal fungi benefit their plants, but the amount of benefit or harm may vary depending upon location, timing, or the mix of species involved (Klironomos 2003). Often, though, the relationship is mutualistic (mutually-beneficial). These relationships between fungi and plants may be as old as the land plants themselves (Delaux et al. 2015). Many of the mushrooms we see on a forest floor are the spore-producing organs of these fungi whose bodies are much larger underground than above ground (see the figure 1 below for examples of St. Andrews mycorrhizal fungi).
Mycorrhizal fungi are ubiquitous in forests across the world. They are often very diverse, so multiple fungal species (perhaps as many as 15 species) may associate with any particular tree (Saari et al. 2005). And, just as importantly, multiple trees may be connected by a given fungus. This leads to a web of underground connections underneath a forest. These connections are important—they are super-highways of information sent between trees and fungi, and between trees. Work out of Suzanne Simard’s lab has shown that large trees nurture their young, sending them excess sugars early in their lives, and making room for them underground. They may also send sugars to trees of other species, and may send other things besides sugars—signaling defense chemicals that could “warn” of insect attack, or other disasters. The trees are sending signals, “communicating” in the language of chemistry, and other trees are receiving those signals, through fungal connections and sometimes through direct root connections called “root grafts” (Tarroux and DeRoachers 2011), across a forest.
Thus, a forest is a “world-wide web” of fungal-tree connections. It is possible that a forest is akin to one large symbiosis—partners in close association, sometimes benefitting, sometimes harming each other—but often cooperating. This also has implications when a tree is cut—cutting will affect the trees around them, often for the worse. Killing a large tree may diminish its seedling’s chances of establishing (keeping a mom from caring for her kids), or may leave other forest trees more vulnerable to future insect attack. Time to check my email (my network of connections) before heading off to bed...

References:
Delaux P.M., Radhakrishnan G.V., Jayaramana D., Cheema J., Malbreil M., Volkening J.D., Sekimoto H., Nishiyama T., Melkonian M., Pokorny L., Rothfels C.J., Sederoff H.W., Stevenson D.W., Surek B., Zhang Y., Sussman M.R., Dunand C., Morris R.J., Roux C., Wong G.K., Oldroy G.E.D., and Anéa J.M. 2015. Algal ancestor of land plants was preadapted for symbiosis. Proceedings of the National Academy of Sciences 112(43):13390-13395.
Klironomos J.N. 2003. Variation in plant response to native and exotic arbuscular mycorrhizal fungi. Ecology 84(9): 2292-2301.
Saari S.K., Campbell C.D., Russell J., Alexander I.J., and Anderson I.C. 2005. Pine microsatellite markers allow roots and ectomycorrhizas to be linked to individual trees. New Phytologist (2005) 165: 295–304.
Simard S. 2016. How trees talk with each other. https://www.youtube.com/watch?v=Un2yBgIAxYs
Tarroux E. and DeRoachers A. 2011. Effect of natural root grafting on growth response of jack pine (Pinus banksiana; Pinaceae). American Journal of Botany 98(6): 967-974.
Critter of the week Installment 14 10-29-2021
Today, in the week leading up to Halloween, I want to talk about pumpkin-colored orchids, a kind of “morgue”, and ghosts.
The orchid is the orange-fringed bog orchid, Platanthera ciliaris. Its Halloween-orange flowers are incredibly showy and beautiful. It lives up to its status as an orchid. And I found it in a morgue. That’s not a flattering way to put it—perhaps a better way to say it is I found it in a kind of museum for preserved, flattened plants called an herbarium. Because an herbarium contains actual dead, pressed plant specimens, it is also kind of like a morgue… At St. Andrews, we have our own herbarium, an amazing collection of specimens, mostly from our local region. Few botanists collect in this area, so our record of what was here (from the early 1900s at Flora McDonald College to mostly the 1980s) is a great treasure trove of information about plants that occurred in this area. If we want to know about where and when rare plants were found, an herbarium is the place to look. If we want to compare specimens of a species to make sure it isn’t really 2-3 separate species we have missed, an herbarium is one place to look. And we have an herbarium on campus—since the flooding after hurricane Florence, over 1/3 of the specimens are waiting in freezers to be restored from flood damage. Prior to the floods, in fall of 2018, I was documenting what we had, and I came upon a ghost—an orange-fringed bog orchid. This plant was collected on St. Andrews campus, on the student side of the lake, in 1982 (Figure 1).
These orchids, and all terrestrial orchids (orchids that grow from the soil), are dependent upon a symbiosis to germinate—seeds are tiny, poorly provisioned by the mother plant, so they have few nutrients and food in the seed for the new seedling to use. Because new seedlings don’t make much sugar from photosynthesis, they would die without a boost from fungi they associate with—a special group of mycorrhizal (root-associated) fungi found in the soil, that associate only with orchids! These fungi invest sugars and nutrients in the growing orchids, and if the plant survives and starts photosynthesizing more, the fungus will eventually make back (in sugars) much more than they invested (Peterson et al. 1998).
But for this story, the more important thing is that this plant is a ghost—it does not occur on our campus anymore. I have never seen it in the wild (in my life, let alone on campus). And the scary part is that this plant is not alone—it is among many ghosts, plants that were here soon after I started teaching here, and that have since disappeared due to herbicides, indiscriminate cutting, or other factors. Our biodiversity is shrinking. I went through the plant list for our campus and estimated that 30-40 native species out of about 534 plant species on campus may well have disappeared in the last 7 years (that’s 5%). We are losing biodiversity rapidly (and who knows how many organisms we have lost that were dependent upon these plants?). If we don’t protect native biodiversity, who will?
On the one hand, how scary can the ghost of a plant be?—what can it do to me? They don’t rattle chains or moan, or pile up furniture when I am not looking… but still, these ghosts of biodiversity lost haunt my days, and terrify me as I try to get to sleep at night.

References:
Peterson R.L., Uetake Y., and Zelmer C. 1998. Fungal symbioses with orchid protocorms. Symbiosis 25:29-55.
Critter of the week Installment 15 11-5-2021
Today, I want to address a potential new species in a large group of symbiotic organisms that could be considered lazy, but in a miraculous way. Imagine you could make food grow into your mouth, and take care of all of your food needs without ever leaving home… Ok, ordering food on the internet and having it delivered during lockdown does not count!
Today’s critters of the week are gall-making insects. If you’ve ever seen strange growths on leaves, stems, or other plant parts, those are galls—they may look like balls or balls on sticks, they may be smooth or fuzzy on the outside, and they come in different colors. They look like they might be strange fruits, but they are not fruits (see figure 1 for examples). They look, for all the world, like tumors on plants. And they are like tumors, usually made by insects.
At least some insects make galls by producing chemicals that mimic plant growth hormones. We have growth hormones that tell our bodies to grow (released at key moments in our development, so we grow at the right time, and the right amount). When we grow, our cells divide and enlarge. If cells divide too much or at the wrong time, this could lead to cancer. Plants also make hormones that tell them when to grow and how much to grow. Gall insects produce chemicals that mimic hormones, so they “control” the plant’s growth (some produce more than one hormone mimic, see Yamaguchi et al. 2012). This accomplishes at least two things: the larva triggers the plant to make a growth that the insect can live inside while protecting itself from its predators, and it makes a constant supply of fresh food, practically growing that food into its open mouth!
There is a large diversity of galls out there—and they are made by a large diversity of insects. Gall-making is a lifestyle, as are many other ways of eating plants. Some flies, wasps, moths, beetles, true bugs, mites (related to spiders), as well as some roundworms, fungi, and bacteria can cause galls to form (Hahn and Ascerno 2019; Smithsonian, Insect and Mite Galls). Not just any organism can do it, even within these groups. Also, the lifestyle has evolved many times, even within some of these groups. Who wouldn’t want a lifestyle like that? Ok you’d have to be really small to do it, and you’d never see the outside world except as an adult, but even so… They are relatively specialized, often forming galls on only one plant species or a few related ones. Often you can even identify a gall-making species by the characteristics of its galls and the plant species it is on—but 800 species are found on oaks, so it can get tricky (Smithsonian, Insect and Mite Galls).
One gall in particular, pictured in figure 2 below, may end up being a new species, discovered on campus. It is likely made by a fly. Its galls look like bottles sitting on top of a water oak (Quercus nigra) leaf—they form over the summer, and mature into the fall. Then the adult (experts think) emerges in spring. I hope I’ll get to find out. I have marked some leaves with these galls (tying the leaves to the tree so I do not lose them as leaves fall), and hope to collect them soon, to keep over the winter and hopefully raise some adults. All I have to do is laze around all winter, waiting for them to emerge! Please pass me the remote...


References:
Hahn J. and Ascerno M. 2019. Insect and Mite galls: https://extension.umn.edu/yard-and-garden-insects/insect-and-mite-galls
Smithsonian Institute, Insects and Mite galls, https://www.si.edu/spotlight/buginfo/galls
Yamaguchi H., Tanaka H., Hasegawa M., Tokuda M., Asami T., and Suzuki Y. 2012. Phytohormones and willow gall induction by a gall-inducing sawfly. New Phytologist 196: 586-595. doi: 10.1111/j.1469-8137.2012.04264.x
Critter of the week Installment 16 11-12-2021
Organisms as hotels for microorganisms, part I.
Plants are a lot like old hotels—they are made of wood, they are tall, and it hurts a lot if they fall on you… Most importantly, plants (for example trees) also house myriad organisms in their many “rooms” made of roots (basement rooms), branches, and leaves (upper leaves might be like a penthouse?). And like many residence hotels, there are some tenants that no one even seems to notice—they are quiet and almost invisible. Amongst the mammals, birds, lizards, and insects that live on and in trees, and amongst the amazing variety of insects living on plants, including those like leaf/stem miners and gall insects living inside of plant tissues, there are many additional small, secret tenants: fungi, and sometimes bacteria, that live inside plant tissues of all known plants. For today, I’ll focus on the fungi, a group called endophytes, meaning “inside plants.”
Fungal endophytes (also called endophytic fungi) are different from plant diseases (although many disease-causing fungi are in the environment as well). Most of these symbiotic fungi seem to live among the plant’s cells with minimal negative effects on the plants they inhabit—fungal endophytes do not cause disease. But what are they doing there? Many biologists think they are like vultures, camping out and waiting for the plants to die. Endophytes aren’t always the fastest-growing fungi out there, so many decomposers can beat them to the dead plants in the environment—but if they are already there in a plant, waiting for the plant to die, then when the plant does die, these fungi will get a head start decomposing them, before they are outcompeted by the faster-growing species (Cline et al. 2018). Some endophytic fungi may be waiting for the plant to get stressed out so they can emerge as diseases… yet most endophytes produce no symptoms at all. In fact, many are mutualistic (with benefits to both partners).
Inside any given plant, there may be one or many endophyte species. In plants that have only a single dominant endophyte, the fungus may grow through the entire plant (even sometimes into seeds), and may confer the plant with tolerance to drought, tolerance to other stresses like heat or salt, or even resistance to diseases (Rodriguez et al. 2008) or herbivores (Clay 1988). Fungal endophytes often produce chemicals that keep herbivores away (pesticides?)—this means that in some cases, the poisons in a poisonous plant are produced by its endophytes rather than by the plant itself! Native Americans in Argentina sometimes used endophytes to escape pursuers, leading them through grasslands with poisonous endophytes. The pursuers would stop to feed their horses on the grasses there, and the horses would get intoxicated and die (White et al. 2003).
Most plants have multiple endophyte species living in them, and the community of endophytes might change depending upon the season or the location (Carol 1995). Even diverse endophytes might help their plant host resist diseases or herbivore attack. They may resist diseases through chemical means or simply by occupying all of the space in the hotel, preventing diseases from establishing (Arnold et al. 2003).
I have only begun to glimpse the endophyte communities of our campus. The endophytes are there inside their plant hotels, and come out if you sterilize the outsides of roots, leaves, or stems (to get rid of contaminants) and put the surface-sterilized tissue on petri plates of food for fungi (like sugars soaked in a gel called agar). Some examples of endophytes that emerged from plants on campus are in the photos below (figure 1). The possible benefits (or costs) of these endophytes in their plants are completely unknown. Another world worth exploring…
References:
Arnold A.E., Mejia L.C., Kyllo D., Rojas E.I., Maynard Z., Robbins N., and Herre E.A. 2003. Fungal endophytes limit pathogen damage in a tropical tree. Proceedings of the National Academy of Science 100(26): 15649-15654.
Carroll G. 1995. Forest endophytes: pattern and process. Canadian Journal of Botany 73(Supplement 1): S1316-S1324.
Clay K. 1988. Fungal endophytes of grasses: a defensive mutualism between plants and fungi. Ecology 69: 10–16.
Cline L.C., Schilling J.S., Menke J., Groenhof E., and Kennedy P.G. 2018. Ecological and functional effects of fungal endophytes on wood decomposition. Functional Ecology 32: 181-191.
Rodriguez R.J., Henson J., Van Volkenburgh E., Hoy M., Wright L., Beckwith F., Kim Y.O., and Redman R.S. 2008. Stress tolerance in plants via habitat-adapted symbiosis. International Society for Microbial Ecology Journal 2: 404-416.
White J.F. Jr., Bacon C.W., and Hywel-Jones N.L. 2003. Clavicitalean fungi: evolutionary biology, chemistry, biocontrol and cultural impacts (Mycology series). Taylor and Francis Group LLC, Boca Raton, FL.
Critter of the week Installment 17 11-19-2021
Organisms as hotels for microorganisms, part II: in which I talk about bacteria, guts, and poop…
This week I’d like to start with a non-native species in the US, but one that has been with humans for a while, and one that looms large on our campus: the horse. Of course I don’t wish to focus on the horse as an organism itself (you know me!), but instead as a hotel for other critters. All vertebrates (animals with backbones), for example horses, are a lot like old hotels… not structurally, exactly, but they do house many small creatures, especially in their guts.
One reason is that many vertebrates are not fully equipped on their own to digest the food they eat—especially if they eat plants. Cellulose (aka fiber) is impossible to digest with enzymes mammals produce. But some bacteria, fungi, and protists can do it. Another reason is that the world is almost blanketed in bacteria (except where we spray our copious antibiotics—then the world is blanketed with antibiotic-resistant bacteria!). That means when vertebrates eat, they naturally take in bacteria (and fungi, and protists) with their food. Taking in bacteria or other organisms like this might seem like a bad idea to human bacteria-phobes. After all, some (a few) bacteria cause disease, and the bacteria in animal guts are eating some of the food in those guts. Yet this “microbiome”, the community of microscopic organisms living as symbionts inside the guts of animals can help their hosts digest food (like cellulose digestion in horses), help prevent diseases (Julliand and Grimm 2016), aid intestinal repair and maintenance (Turnbaugh et al. 2007), produce vitamins like vitamin B (e.g. Gominak 2016), and more. It is usually much more of a mutualistic than a parasitic relationship.
And the microbiome is diverse—it is diverse in us, and also in horses, and other organisms from which microbiomes have been studied. At least 50 species of protists, 5 species of fungi, over 30 species of bacteria, many unknown types of a group called Archaea (including methanogens that make methane), and perhaps over 60 species of bacteriophages (viruses that infect bacteria) may reside in a horse’s gut (Julliand and Grimm 2016). The gut-dwelling critters are abundant as well. Bacterial cells may be as numerous as the body cells of the vertebrates they inhabit (Abbott 2016). Also, different organisms have different microbiome communities, and closely related organisms tend to share similar types of gut community members (Field Museum 2020).
Horses are hindgut digesters—most of their gut microbiome is in their hindgut, digesting cellulose a bit late in the game… This is in contrast with foregut digesters like cows. That’s why we can see bits of grass in horse poop but not in cow poop… Horses are less efficient digesters of cellulose due to the placement of their gut community—and they need to eat more to get the same amount of energy out of their food. Recent research suggests that bats and birds have a more diverse (and varied) gut microbiomes, in part because they may just be picking up whatever microbes they ingest with their food, and getting rid of it when they defecate. Perhaps they do not need the extra weight when they fly (Field Museum 2020). This could mean that other vertebrates select which microbes stay and which will be ejected from their guts? Or the gut community members select amongst themselves, some staying, and others getting ousted?
Of course, another reason why I am writing this is to highlight what we don’t know. Since the 1990s, we have studied the diversity and functions of gut communities of humans, cows, horses, and a few other organisms in detail. Yet other vertebrates and many invertebrates (for instance insects, like termites) have gut communities, and we are only beginning to uncover the secrets hidden within those communities. That’s it for this installment—off to Thanksgiving break so I can feed my microbiome!
References:
Critter of the week Installment 18 12-03-2021
Of moth-pollinated grasses and false accusations of witchcraft…
Stories are everywhere in nature if you know where to look, and if you make a reasonable assumption that most organisms are in a place for a reason. I am sure I miss so many stories, but I manage to catch a few, like the other day when I saw a moth on a stalk of grass (Figure 1 below). Perhaps at first glance, this does not sound like much of a story… Let me assure you that this “moth on a grass” is an amazing story. It’s one I hadn’t thought about in a few years, and it is worth retelling here.
I’ll start at the beginning, with flowering plants. Plants are really good at getting other organisms to do things for them. Most flowering plants need insects to move pollen from plant to plant, which enables plants to produce seeds. Most flowers include advertisements to get insects to come, and many include “rewards” to keep them coming. This is plant sex, done through a mediator (a pollinator, in this case). Pollen contain sperm, so pollinators are moving sperm from male parts of one plant to female parts of another. Incidentally, plants also get animals to disperse their seeds, getting plants to new places—another example of plants getting other organisms to do things for them. Who says plants can’t move? We are no different—we get cars and airplanes to transport us further and faster, even though can move ourselves.
Back to pollination, and the moths on the grass—so the moth was pollinating the grass? Not quite. The funny thing is that many flowering plants have secondarily evolved wind pollination. This means that although their distant ancestors were insect pollinated, many groups of plants evolved wind pollination. Grasses are one such group. Wind pollination is favored in the windy open places in which grasses tend to grow. Wind pollination tends to be associated with small, inconspicuous flowers that produce no nectar, and relatively small pollen that catches the wind. Grasses are no exception. So now it should seem more mysterious that a moth would be hanging out on a grass, feeding—feeding on what, exactly?
It turns out that some fungi are also very good at getting other organisms to do things for them. The grass I saw, called victory grass or Bahiagrass (Paspalum notatum, an introduced plant from South America) is infected by a symbiotic fungus, Claviceps paspali, in a group of fungi that are good at infecting grasses, taking over seeds, stealing sugars from the plant, producing some of their own sugars, and making “nectar” that attracts moths and other insects. The nectar has fungal spores in it, so somewhat like a venereal disease, Claviceps (or ergot) fungi get moths to transmit the disease from grass to grass. It is strange, seeing grass loaded down with moths on a late summer or early fall night. I haven’t seen it much on campus, but it is here. In other places, there’s a bright orange fungal parasite of Claviceps called Fusarium heterosporum that grows on the fungal “nectar”—its spores are also carried by moths (Feldman et al. 2008 and references therein, Figure 2 below).
A few decades ago, ergot fungi were accused of causing the Salem witch trials of the late 1600s, when men and women (mostly women) in Massachusetts were falsely accused of being witches (19 of them were hanged). It turns out that when people eat bread made with ergot-infected grain, it gives them some of the “symptoms” experienced by “victims” of the supposed witches. It is still unclear whether this is a plausible explanation—we don’t know whether ergot poisoning played a role in the witch trials, or whether they were caused by purely human problems (Mundra et al. 2016; Spanos and Gottlieb 1976; Wikipedia; Woolf 2000).
So who knows? When you see a moth on a stalk of grass, or hundreds of other things you might see out there, I hope you’ll think twice before you write it off as boring or not worthy of notice… After all, the other day when I saw a moth on a grass stalk, I really saw a moth taking nectar from a fungal “venereal disease” on a grass while spreading fungal spores to other unsuspecting grasses… These stories are happening all around us.
References:


Critter of the week Installment 19 12-10-2021
Viruses that “befriend” a fellow parasite?
In this crazy world, so much is possible. Yet in these days of Coronavirus, our sense of the possible sometimes feels shrunken, as we have been more restricted in so many ways (yet a vaccine came out in only about a year—that is pretty amazing). Either way, with all of the horrible COVID-related news, it is especially hard to imagine any organism teaming up with a virus that helps their survival. That seems crazy! Yet there is a group of organisms that does just that, and members of that group occur on campus.
Earlier this year, around the same time as I was writing about a cuckoo wasp that was trapped in the building and dying on windowsills, fellow faculty member Valerie Kline noticed another critter that had gotten itself caught in the building. When she sent me a photo (Figure 1 below—that is her photo), my mouth fell open. It was a giant Ichneumon wasp, genus Megarhyssa, probably M. macrurus. I hadn’t seen one of those for many years. They are big wasps, almost 2 inches long, with a needle-like ovipositor (organ for laying eggs) over twice as long as the body, trailing behind as they fly. Luckily, it was still alive and I managed to catch it in an insect net and set it free—These wasps look scary but are completely harmless to us. Eventually, if left unattended, it would have died trying to escape, or someone would have killed it.
Ichneumon wasps and the related Braconid wasps are parasitoids. They insert their ovipositors into other insects (larvae) and inject an egg. The egg hatches and eats the host insect from the inside out, eventually emerging, either right before or right after pupating (becoming an adult). The host insect dies, but not until after the Ichneumon (or Braconid) wasp inside completes its development. Many a time I have tried raising an adult of a leaf-mining insect, only to find a braconid wasp parasite emerge instead of the moth or fly I was expecting. The giant Ichneumon wasp in the photo parasitizes larvae of a group of wood-eating wasps called horntails that burrow deep inside of trees. The Ichneumon female can sense where the horntail larva is in the tree (hearing their vibrations? Smelling their poop?—The Bug Lady 2014), and uses its long ovipositor to reach into the burrow and lay its egg on the host (High Plains Integrated Pest Management, Senza 2016). In some senses, these wasps are symbionts, as they live in close association with their hosts, living inside them for some portion of their lives—yet they grow up to be free-living adults.
One problem: hosts have immune systems, so how can the wasp remain inside the body of their host for so long (and it may take longer for the host to develop while the parasitoid wasp is eating them) without being detected (and destroyed) by the insect host’s immune systems? Ichneumon moms inject immune-suppressing venom while laying their eggs in hosts. Some Ichneumon and Braconid wasps have an even cooler way of remaining undetected, involving viruses called “polydnaviruses.” The females of these wasps inject virus particles with their eggs. Once in, the virus does not reproduce. Instead, its genes are turned on inside the host, helping to change the host to make them more “welcoming” to the larva (Volkoff and Cussan 2020). It seems the virus’s normal function has been suppressed—one reference used the word “hijacked” or “domesticated” (Herniou et al. 2013)—to work for the parasitoid wasp. The virus particles are passed from the mother wasp to her offspring, like her own genes are. It’s almost like the virus has become part of the wasp, and they function together, albeit they are working together to slowly and agonizingly kill a host—but still!
There are at least a few examples of viruses teaming up with organisms in ways that help the organisms. One example that hits close to home is a gene that makes part of the human placenta (the interface between the mother and the child). Studies have shown that the gene is of viral origin (Chuong 2018, Ryan 2004). It helps keep the mom’s body from treating the baby inside her as foreign tissue. Yes this means we are part virus too!
One lesson is that even our worst “enemies” may not be enemies for all of evolutionary time.
Off to get yet another COVID test…
References:

Critter of the week Installment 20 12-17-2021
This week, I explore the biology of a favorite Holiday parasite…
At this time of year the leaves of most trees have already fallen, revealing balls of leafy green on the trees (Figure 1A). If you look closely (Figure 1B), you’ll see that the leaves associated with those balls of green are not the same as those of the tree on which they grow. You are looking at a plant called mistletoe, or Phoradendron leucarpum (yet worldwide there are many plants with similar growth habits in at least three plant families that are called mistletoe; Barlow 2012). Perhaps you’ve kissed under mistletoe before. What is it doing up in a tree? The short answer is that it is a parasite! The long answer opens the door into a crazy story, playing itself out right now, in the trees above you.
Mistletoe plants are green—probably one of several reasons why people gravitated toward them as a plant of winter celebrations. This means they make their own food by photosynthesis, using solar energy to build sugars from carbon dioxide in the air. So why are they parasites if they make their own food? The answer is that they need nutrients and water as well, and they get that from the plants they parasitize. This is called hemiparasitism, or “half parasitism” because they make their own food yet still parasitize other plants. They are evergreen, making the best of shaded conditions in the summer in the midst of their host tree’s leaves, and making slow use of the winter sun when their host trees are bare (photosynthesis goes slower in winter, so many plants don’t bother to keep their leaves around, given the costs of water loss, etc.).
The seeds germinate, sending root-like structures called haustoria into the branch, possibly using enzymes to break the tissues of their plant hosts on their way in (Barlow 2012), to connect with the xylem of their host plant. Xylem is a tissue made up of specialized cells for carrying water and nutrients in a one-way trip throughout most plants from the roots to the leaves. I imagine that the host plants, if they could, would scream in agony, or would at least scratch themselves. Secretions from the mistletoe stimulate the plant to make more xylem too (Barlow 2012). Mistletoe can parasitize many different species, yet seems to “prefer” certain species in any given environment (their preferences vary with environment). Here they seem to prefer red maple (Acer rubrum), but they are on at least a few different types of trees on campus. They sense the “right” plants through chemical cues their hosts release into the air around them (Randle et al. 2018).
Mistletoe blooms in the late fall/early winter. It starts flowering the fall, between September and October (Plants of Southern New Jersey, 2010)—the flowers are inconspicuous (Figure 1C), pollinated by flies, and possibly by wind. (Ollerton et al. 2016). Berries mature by wintertime (when no host tree leaves are in the way), and they are conspicuous, white on green—attractive to birds that eat the berries and disperse the seeds (Figure 1B). Birds are a good vehicle for seed dispersal—they can travel far, and they perch in trees where mistletoe grows. But there is more to the story: the fruits and seeds are sticky (Figures 1D and 1E), so when they pass through the bird gut (birds pass seeds through pretty quickly), they stick to the bird’s behind. To get them off, the birds often rub their bottoms on the tree branches (giving the mistletoe its name: a corruption of “mistle tan” or “dung twig”, Schalau 2019). Sometimes birds may regurgitate the seeds, rubbing them off of their beaks onto the branches after swallowing the berry (Sutton 1951). This is a wonderful example of directed dispersal—the plant’s adaptation of sticky seeds gets the birds to put the seeds in a place that works best for the mistletoe. Thus, as with most plants, mistletoe plants are dependent upon several mutually-beneficial relationships (mutualisms) in addition to parasitism.
So next time you kiss under the mistletoe, just think (or try not to think) of the flies, bird droppings, and haustorial connections that made this all possible…
References:

Critter of the week Installment 21 1-14-2022
“I know we’re termites. But if all the termites got together, the house would fall down.”
--Florynce Kennedy, American lawyer and civil rights advocate
This week I wanted to pay homage to termites—a strange group of insects most people view as pests, worthy of extermination and little else. Yet termites are amazing critters. I use them every semester (if I can find them) as an introduction to my non-majors intro-biology class, to stimulate their curiosity and teach about the scientific method (as demonstrated to me years ago in a workshop by renowned science educator Diane Ebert May). I place a termite on a large piece of paper, and draw a line with a ballpoint pen in front of it. Then the termite follows the pen lines. Hopefully, students ask why. We generate hypotheses, try different pen colors, types, etc. And hopefully they will get closer to the best supported explanation (spoiler alert): they are following the smell of ballpoint ink. A chemical in ball point pen ink mimics a chemical produced by termites used to help them tell where other termites have been, so they know where to go or how to get from place to place—called a “trail pheromone” (pheromones are chemicals used in communication between members of one species). Termite workers and soldiers spend most of their time in almost complete darkness (mostly underground near wet wood, or inside the itself), and they are blind (entoweb, OK state). Sometimes a loss of a trait can be an advantage. Termites that spent less energy maintaining eyesight may have done better than others because they could use that energy to do more pressing things. If they never use their eyes, it is a waste of energy to keep them working. Many insects, even “sighted” ones, use their sense of smell much more than we do, and chemical communication is extremely important for insects.
Termites are social insects—they have colonies in which different individuals perform different specialized roles. Termite societies are completely separate from the societies of ants, bees, and wasps. Queens and kings, the only reproducing individuals in the colonies, produce eggs that develop into workers or soldiers. Workers get food, feed the king, queen, and growing nymphs by regurgitating food into their mouths, and maintain the colony. Soldiers defend the colonies and warn of danger through vibrations caused by banging their heads on tunnel walls, and escort workers on foraging trips (Orkin). The kings and queens also produce reproductive individuals that can replace queens or kings if they die, or fly off to new places to start new colonies (entoweb, OK state).
The main thing people know about termites is that they eat wood. Yet few (if any) insects and no vertebrates (animals with backbones) can digest wood on their own, because it takes special “tools” to do it. In almost all cases, symbionts are involved. In these termites, protozoans living in their gut produce a chemical (an enzyme) called cellulase that breaks down cellulose (Vehkaoja 2019). In other wood-digesting insects, fungi or bacteria are involved—and the coolest part is that the 20 insect families with wood-digesters are not all close relatives. This means that many of these 20 families have separately evolved to team up with wood-digesting symbionts (Vehlkaoja 2019).
And although we find it very problematic when we try to own and keep homes made of wood, wood digestion plays an important role in ecosystems. Trees fall, and the wood makes homes for myriad organisms. Bacterial types living in termite galleries may be different than those in the surrounding environment (Soucup et al. 2021). As the wood is digested by termites and other organisms, the nutrients in the wood eventually go back to the soil, where plants can access them again. Termite tunnels (and tunnels of other soil insects) aerate the soil, make it easier for roots to move through, and help the soil retain water (Culliney 2013). It’s difficult to think about termites as helpful, yet they are extremely helpful in non-human systems.
So maybe one could amend Florynce Kennedy’s famous quote: “…if all the termites got together, the house would fall down”, walking through the woods would be nicer (no large piles of logs in the way), and the woodlands around us would be thriving and green.
I hope she wouldn’t be disappointed with the addition, which reflects the strong connections between the environmental movement and the civil rights movement (the environmental justice movement; EPA Environmental justice timeline).
References:

Critter of the week Installment 22 1-21-2022
One thing about life is that it doesn’t fit neatly into categories. It always helps us humans to have clear dividing lines, especially when we are trying to make the unfamiliar familiar. Yet life often doesn’t follow the neat dividing lines we construct. For instance, plants—they are green and make their own food—right? That is, except when they don’t. Some plants are parasites, and have little/no chlorophyll at all, and instead get their food from plants they parasitize. We have one of those types of parasitic plants on campus (called dodder), and that one will have to wait for another day. Today’s critter of the week is stranger than that.
Cephaleuros virescens, the critter of the week, is an alga. Algae were the first plantlike organisms in the water, long before some land plants re-invaded the water and evolved into aquatic plants. Most algae still live in water. Yet there are also some green algae that make their living on top of land-dwelling organisms—just harmlessly using them as a surface to grow on. You might sometimes see shelf fungi growing out of a log that are greenish because algae are growing on them. Species in the genus Cephaleuros go a step further, not only living on land (usually on leaves of evergreen plants like Southern magnolia) but also appearing grey or red-brown instead of green—this is a genus of land-dwelling parasitic green algae. So it is weird. Yet its DNA, cells, and growth form tell you it is an alga. Cephaleuros virescens is one species of these parasitic green algae that I know of on campus—it parasitizes southern magnolia (Magnolia grandiflora), yaupon holly (Ilex vomitoria), and a few other plants with leathery evergreen leaves. Its body looks fungal: rounded grey masses of algal filaments flattened up against the upper surfaces of leaves they parasitize (Figure 1), living just under the waxy outer leaf layer called a cuticle. The cuticle protects leaves from water loss. C. virescens usually does not cause much damage to plants (Nelson 2008). This may be all the better for the parasite, as it requires a living host for its life cycle.
It isn’t even clear whether Cephaleuros is a plant, due to semantics about where people draw the boundaries around the group of organisms they call plants. For instance, some people group green algae with plants, while others prefer to exclude algae from the plant group, including only land plants. Several green algal groups branched off the same family tree, earlier than land plants, and it’s pretty certain that the ancestor of land plants looked like a green alga. So some people include the whole thing, land plants and algae, together in one group called plants (Judd et al. 2016).
Cephaleuros are carried to new host surfaces by wind and rain, releasing cells called zoospores that penetrate the cuticle in the leaves, germinating into a threadlike algal body. Infections are more common in wet warm weather (and the alga cannot complete its life cycle without a film of water laying over it), yet infections are easy to see on plants even into the winter. This alga can survive in leaf litter once the infected leaves fall (Nelson 2008).
I like that life does not fit neatly into categories (maybe reassurance for me when I feel like I don’t fit into societal categories). Either way, for me it is more interesting, and expands my sense of what is possible.
References:
Nelson S. 2008. Cephaleuros species, the plant-parasitic green alga. Plant Disease PD-43, Cooperative Extension Service, College of Tropical Agriculture and Human Resources, University of Hawai’i at Mānoa.
Judd W.S., Campbell, C.S., Kellog E.A., Stevens, P.F., and Donoghue M.J. 2016. Plant Systematics, a phylogenetic approach, fourth edition. Sinauer Associates, Inc., Sunderland, MA, USA (ISBN # 978-1605353890)

Critter of the week Installment 23 1-28-2022
Sometimes in life it is good to take a longer view. Sometimes I feel impatient to solve natural-history related mysteries around me, when successes are difficult to come by. On top of that, in winter, I sometimes feel impatient for more life to return to the world. Yet I try to remember that many organisms are going about their business, quietly, even in the coldest months North Carolina has to offer. One amazing group of organisms active over the winter include members of a genus of miniscule moths called Marmara. The adults of these moths are beautiful, with wings patterned with whites and browns, sometimes sparkling or with little hints of iridescence (Figure 1). Yet they are tiny—only 3-4 millimeters long. The larvae of many of these moths spend their winters mining through stems of plants, feeding on plant tissue just under the surface. Marmara species are among the most mysterious of all of the mining insects I have observed.
I remember learning about stem miners from my colleagues Charley Eiseman and Mike Palmer. At the time, I was just learning about leaf-mining insects, critters that spend their larval lives in the tiny thin space in between the top and bottom surfaces of a leaf, “mining” their way through the internal leaf tissue. They are small enough to be able to fit, and the adults are often tiny as well. Yet I hadn’t realized that they could mine stems too. It was winter when I started looking at all the trees on campus, to see if I could find “trails” made by the larvae of these critters on trunks and branches. The more I looked, the more I’ve found (Figure 2A and 2B). I’ve since found their trails on 16 species of plants on campus, including trees, shrubs, and even herbaceous plants (and 24 species of plants in North Carolina in general). The majority of these moth species are likely to be new to science. Yet in order to confirm that they are new species, it is important to document adults raised on a given plant, but it is very difficult to raise them to adulthood.
One problem is that they are like needles in haystacks… Yes, the trails can be difficult to spot, but the bigger problem is that they are often infrequent. Several of the Marmara trails I have found only once on a given species of plant. Very often I see them one year and then not again for many years.
A second problem is that many of these are growing in branches of trees. Usually, with leaf miners, I can collect a leaf and put it in a vial, then watch the entire life cycle unfold in that tiny space. Yet one cannot as easily collect a tree… or even a large branch.
A third problem is that it is often unclear how long it takes for these miners to emerge. The basic life cycle for many of these stem-mining Marmara species is that their eggs hatch in the summer or fall, and the larva starts mining through the stem. They continue to mine down the stem during the late fall and winter, sometimes in a winding trail that doubles back on itself or forms loops. Then, at some point they either form a flap of bark under which they build a cocoon and pupate (the stage in which they transform into an adult), or they emerge and make a cocoon somewhere else, on the trunk of the tree or in the leaf litter below (Eiseman et al. 2017). Then adults emerge a couple of weeks later. During most of that time, they need the fresh food provided by the stem. If we don’t know when they will emerge, or where, then we could easily cut the stem too soon. If we wait too long, the larva might emerge and pupate where we’ll never find it.
Because this is running a bit longer than I’d anticipated, I will continue this next week. In light of taking the long view, I hope you’ll stay tuned until then. I’ll talk about successes with these elusive creatures, and even more stunning failures.
References:
Eiseman, C.S., Davis, D.R., Blyth, J.A., Wagner, D.L., Palmer, M.W., and Feldman, T.S. 2017. A new species of Marmara (Lepidoptera: Gracillariidae: Marmarinae), with an annotated list of known host plants for the genus. Zootaxa 4337 (2): 198-222.


Critter of the week Installment 24 2-4-2022
This is part II of “taking the long view,” about Marmara moths, successes, and failures…
One year I had amazing luck with stem-mining moths. On winged elm trees (Ulmus alata), I found trails (mines) and followed them to their ends (Figure 1A), then looked around on the trunk of the tree until I found their tiny cocoons (Figure 1B). Their cocoons are weird, as the larvae make something called “frothy bubbles”, tiny balls that they push to the outside of the silk of their cocoon before pupating inside (Eiseman et al. 2017; Figure 1C). To my knowledge, no one knows what purpose the frothy bubbles serve. I tried to find cocoons on trunks near similar mines on sweet gum trees (Liquidambar styraciflua), but had no such luck—those miners do not build cocoons on the tree trunks. So I took a chance and collected some stem sections with mining larvae in bags, and one larva emerged and spun a cocoon on the surface of the bag. In a couple of weeks, adults of both the elm and sweetgum miners had emerged (Figure 1D and 2)—two hard-won successes in the midst of many failures.
I believe it was later that year my luck continued, and Charley and I also managed to raise adults a leaf-mining Marmara species from Passion flower (Passiflora lutea, Figure 3)—I have only ever found that one on campus so far, and only during a narrow time window in mid-summer.
There are many more Marmara species out there that are still known only from trails on plant leaves or stems (at least 10 species in North Carolina)—some are so infrequent I may never find them again. Some occur regularly but I haven’t gotten the timing right. Some mine from a leaf into a stem, sometimes with mines deep enough that I cannot see them on the surface, and it isn’t clear when or where they will emerge.
One of my most stunning failures so far has been with the first Marmara I ever “discovered”—the species that hooked me on leaf miners in the first place. I was looking for a lab topic for my ecology class, and came upon a leaf miner on a plant called horse sugar (Symplocos tinctoria). I could find no one to identify it, until a friend of mine put me in touch with Charley Eiseman, who writing a book on leaf miners of the US. He said it might well be a new species, and my jaw dropped—I had always dreamed of discovering a new species, but never imagined it would actually happen, much less in North Carolina. The thing about this species is that it mines from leaves into stems (Figure 4), and stem trails are difficult to follow (I am not sure how the larvae know which way to go as well, as the mines wander quite a bit before heading down the leaf petioles (stem) into the branches). I tried all sorts of things like searching for trails on stems, and cutting stems and putting them in water or in net bags. I tried digging up small trees with miners on them and placing the trees in large net cages designed for butterflies, then looked for the 3-4 millimeter-long moths among the leaf-litter in the cage later on (talk about a needle in a haystack…). I tried putting net bags over small trees in the woods, hoping to find dead moths in the net at the end of the season. So far nothing has worked…
As many Marmara caterpillars make their long, slow passage through stems in the dead of winter, I too must take the long view, thankful for the occasional break-throughs whenever they may happen.
References:
Eiseman, C.S., Davis, D.R., Blyth, J.A., Wagner, D.L., Palmer, M.W., and Feldman, T.S. 2017. A new species of Marmara (Lepidoptera: Gracillariidae: Marmarinae), with an annotated list of known host plants for the genus. Zootaxa 4337 (2): 198-222.




Critter of the week Installment 25 2-11-2022
“I
tried to leave but twelve-headed Cerberus is holding me at bay
The trucks zoomed by and I know that I am doomed to forever stay
Death, thou comest when I had thee least in mind
I was cut down in my prime
Sentenced to stale rolls and warmed-over casseroles
Until the end of time”…
…“Waitress,
waitress, bring me some coffee, make it as hot as you can!
And bring me a light for this everlasting night
At the Highway Cafe of the Damned”
--the Austin Lounge Lizards (Highway Café of the Damned)
I’ve previously talked about stories in nature—sometimes the stories aren’t pretty. Imagine an unsuspecting customer out to try a new restaurant with a group of friends… The food smells delicious, the ambience is hip, and they sit down to eat what will be their last meal… They have entered the “restaurant of doom”, and never leave the place alive…
I know it sounds like a plot from a B horror movie (or song, as above). This real-life tragic “horror” story involves a beaver, a tree, and lots of millipedes.
Beavers (Castor canadensis) are one of many engineers of the animal world. They can cut trees to build dams that create ponds in which to build beaver lodges (well-protected homes to settle down and raise kids—beavers are monogamous, by the way). They eat lots of vegetation, which in the winter is harder to come by. But their powerful (and orange) incisors can bite into tree bark, allowing them to eat a food source both rich in sugar (the inner bark includes the sugar-carrying tissues called phloem) and relatively unavailable to many other animals. Of course, they have microorganisms in their digestive tract to help them digest the woody tissue (Anderson 2002). Beavers are common on our campus (Figure 1A), and many a late night I have jumped out of my skin after exiting my office and hearing beavers slapping their flattened tails on the lake when I startle them.
By cutting off the sugar transport to the trees they eat, beavers also end up killing trees, if they eat all the way around its circumference. Trees girdled in this way cannot send sugars up to build new leaves in the spring, and cannot get sugars from leaves during the growing season for winter storage, so they starve to death. Once, last year, I noticed a large sweetgum tree (Liquidambar styraciflua) that had been nearly girdled by beavers (Figure 1B and 1C). It hasn’t died yet, and I think it survived the attack because it was not damaged all the way around its trunk. Still, sap and chemicals called resins (or storax) dripped down the trunk from the girdled parts (resins are medicinal for us, and used by the tree as a defense against fungal diseases; Lingbeck et al. 2015; Lee et al. 2009; Onaran and Bayar 2016). They leaked out in streams over the girdled portion of the tree. This is the restaurant of doom.
Enter the customers, including millipedes… Millipedes are distinguished from centipedes by, among other things, two pairs of legs per body segment instead of one pair, and slower movement. They do not have 1000 legs. Millipedes are herbivores, feeding on rotten plant matter, the more decayed the better (Sakwa 1974). They often curl up tightly with their heads in the center as a means of protection, and also often produce poisons like cyanide. Yet those defenses would not protect them in the restaurant of doom. Millipedes are also attracted by sugars (Sakwa 1974), and sugars occur in the resins released by sweetgum trees. Yet the resins are like amber before it becomes fossilized—sticky… I went out last week to look at the winter-dormant, beaver-chewed tree, and found many dead creatures that had been caught in the sticky resins exuding from the trunk. Most were garden millipedes (Oxidus gracilis) and pill bugs (isopod crustaceans in the family Armidillidiidae), with a few carpenter ants (Camponotus) and other insects thrown in (Figure 2). All (over 20 millipedes and even more pill bugs) had died while searching for food, following delicious smells to their deaths. I came away feeling as if the victims in this tragic graveyard deserved some kind of memorial. It is odd that they are attracted to sugars but do not avoid deadly resins. Perhaps this kind of situation doesn’t happen often enough to be a major source of mortality, even though this well-preserved carnage was more obvious to me than predator-killed millipedes might be. Although it isn’t clear that millipedes are common in amber, they have been found there at least a few times (Riquelme et al. 2014; Zherikhin et al. 2009) and pine resins (Santiago-Blay et al. 2002). Other organisms expose sap and resins like beavers inadvertently do (I’ll talk about woodpeckers called sapsuckers that do this in a future post), with similar consequences.
Next week, I’ll plan to talk about something less scary and more appropriately related to love. Meanwhile, I’ll eat my lunch in my office, thanks very much.
References:


Critter of the week Installment 26 2-18-2022
This post addresses mollusks, sex, and parasites…
Every semester, I take non-majors biology students out to observe the world around them. I hope that if they look closely at the world, they will start asking questions about what they see. Given my interest in finding cool critters, one ulterior motive for these exercises is to have more eyes looking for cool organisms. I keep lists of organisms in different groups, including plant groups, insect groups, birds, mammals, fishes, reptiles and amphibians, and mollusks. After almost 8 years of keeping lists, more and more time goes by between each new added species. Then, during a lab, one student named Savannah asked “what is that on the tree trunk?” She pointed to a group of small snail shells, mostly empty, clinging to a southern magnolia tree (Figure 1).
Because I know next to nothing about snails and slugs, I’ve had to rely on tremendous help from experts like Amy Van Devender (and her husband Wayne) for identification—they even came to campus a couple of times to search for snails. At of the start of this year, 30 species of mollusks had been recorded from campus—these are mostly land snails, snails that complete their life cycles on plants, under logs, or in leaf litter. The list includes six species of “microsnails”, snails that are only a couple of millimeters long at adulthood—you have to spend long hours sifting through soil and leaves to find them.
I collected some of the shells from the tree, and sent photos to Amy. In response, she asked me to send shells to her, which I did. These snails, called succineids or amber snails, are small (about 1 cm long), but vary a bit in size. Their shells are very delicate and thin—they seem likely to crumble or shatter at the least provocation. They sometimes climb trees, but are also found in leaf litter and on smaller plants. They breathe air with lung-like structures instead of gills, thus, they are in a group called the pulmonate snails (Nordsieck 2011). Amy’s best guess was that was that the snail Savannah found was Succinea indiana, or the xeric ambersnail—it isn’t one I’d found on campus before. Oh, and these snails are hermaphrodites.
Although hermaphroditism occasionally occurs in humans, it is very common in some other species—including the majority of plants, some fishes, mollusks, and many other critters. Often, hermaphroditic animals are one sex or another, depending upon conditions—for example, fish may switch from male to female or from female to male—they may replace females that die, or may respond to environmental cues like temperature (and yes, gender in these species is affected by global warming) or pollutants in the water (Cormier). Yet some of these succineid snails are reciprocal hermaphrodites, meaning that they may be both male and female at any time. In one other well-studied amber snail, Succinea putris, they inseminate each other reciprocally, each simultaneously injecting sperm into the other (Dillen et al. 2009). They vary in size, and often smaller individuals pair with larger ones. In nature, the smaller ones may take on more of a male role (as the larger one has more resources to produce eggs), but in some lab experiments, both partners ended up producing eggs and offspring after a mating. Perhaps isolating individuals from each other after mating led them to take on more female characteristics in the lab (this could be beneficial, as it would increase the local populations when individuals are isolated), but it is unclear whether that happens in nature (Dillen et al. 2010). In addition, they can fertilize their own eggs with no partner at all (Dillen et al. 2009), reminiscent of the back-up (reproductive insurance) mechanisms in violets discussed in Critter of the Week installment 2.
Humans sometimes seem very concerned with defining how we are supposed to pair up. Although we’ll never figure out the societal norms of these snails, they at least do things differently… It feels like Succinea have achieved a mutuality in mating that is almost unparalleled.
One other thing: Wayne Van Devender, who took the amazing photo below (Figure 2), pointed out that three of the shells I’d sent them had empty pupa cases of flies inside them (Figure 2 B). At least a couple of groups of parasitoid flies attack snails—they are called parasitoids because, unlike parasites, these end up killing their hosts after eating them from the inside out. It is quite possible that these flies had been inside the snails when they were alive. Hopefully I’ll find out what those are one day…
Meanwhile, the year is advancing toward spring at what seems like a snails pace—time to get out and look for more critters!
References:


Critter of the week Installment 27 2-25-2022
The neighbors down the way… always loud and obnoxious, shouting at each other—that is, when they aren’t sneaking around trying to steal something. They are hoarders… but fiercely faithful to one another. And through their hoarding project, they will inadvertently build a forest...
These complex characters are blue jays (Cyanocitta cristata), common birds across the eastern US. Their numbers are decreasing overall (as with most birds in North America; American Bird Conservancy 2019), but their populations are spreading into Texas, perhaps as a consequence of urbanization (Hutchinson and Scalise 2019). I often hear them trumpeting their own obnoxious calls as they fly from tree to tree. Other times, I hear them make a call that sounds like a red-shouldered hawk—they are also known to imitate eagles or red-tailed hawks. All of this serves to terrorize other birds into dropping their food so blue jays can steal it (American Bird Conservancy 2019). They (and their relatives) can also be eerily silent. I recall working a job looking for bird nests in western Washington state—we had to make sure to check areas we knew had no nests at all before we checked actual nests, just in case gray jays or Stellar’s jays were watching—otherwise, they’d come back later and eat the eggs. As urbanization advances, some endangered birds like rare golden-cheeked warblers in Texas are further threatened by blue jays eating their eggs (Hutchinson and Scalise 2019).
Blue jays mate for life (American Bird Conservancy 2019)—that is actually unusual in the bird world, which is often rife with especially male infidelities (Ford 1983, Arnqvist and Krikpatrick 2005). The reason is that for many species, the goal is to pass on their genes as often as possible—for male birds, for instance, that might mean mating with as many female birds as possible. Scientists have uncovered evidence of infidelity in many birds (Ford 1983, Arnqvist and Krikpatrick 2005). So if infidelity is so beneficial, when/why are birds faithful? One possible answer is that there can be costs to infidelity—perhaps stresses associated with sneaking around, but even just costs of being with unfamiliar partners. In one study of a monogamous goose, birds that lost a mate and found a new mate were less likely to breed, or even to survive (Leach et al. 2020).
So blue jays stay in pairs or family groups (Racine and Thompson 1983), and this may be beneficial for them, in part due to their feeding habits. When blue jays aren’t raiding bird nests, they are often seeking acorns (of many oak species), hickory nuts (of many species), and other large tree nuts. They eat what they need to and take the rest away (in a special throat pouch) to bury it for later. This is called caching, and blue jays and their relatives work hard to move acorns to burial sites that serve as a storehouse of winter food supplies. Blue jays can bury thousands of acorns (Darley-Hill and Johnson 1981). Birds that cache like this often guard these caches from spies (unrelated jays or squirrels) who watch them bury their treasures and steal them when no one is looking (Dally et al. 2006). Perhaps their fidelity is necessary, as they need trustworthy labor and help build and maintain their caches. Other reasons are certainly possible.
So as they work, they also bury some acorns that end up staying in the ground. Perhaps the jay forgets where they put a few of their buried nuts. Perhaps the jay who buried them gets eaten by a predator or killed by a disease. Or perhaps some jays have all they need for the winter, and do not unearth all of their hidden acorns before spring resources (insects, etc.) become more abundant. In a few cases, not even small mammals steal them. Either way, some of those acorns start to grow. The jays have moved them to new places, spreading the seeds to create oak forests where pine forests once stood, moving the seeds far from where that tree species was before, expanding its range (Darley-Hill and Johnson 1981; Johnson et al. 1997). In this way, a group of jays, working together, inadvertently creates a forest. Some scientists argue that blue jays may have helped oaks and related trees “move” to recolonize areas decimated by glaciers after ice ages (Johnson and Webb 1989).
Humans are perhaps the most industrious creatures, with the greatest power to influence habitats on earth. As a human, watching the destruction of habitat after habitat, species after species, by the hands of other humans, I can only hope that one day, we can apply our obnoxiousness, our sneakiness, intelligence, and industrious nature in a more concerted way to create something even half as beautiful and rich with life as an intact oak/hickory forest… Or even to let such things be, and to preserve what we have on Earth.
References:
Critter of the week Installment 28 3-4-2022
In this post, I discuss less visible harbingers of spring. Then I cough and hack…
In winter, I am always looking for signs that spring is on the way. People commonly look for harbingers of spring—showy flowers, trees transformed by the myriad greens of new leaves, migratory birds returning and staking out territories, etc. Yet many signs of “spring” (or at least signs of another coming growing season) may come in small packages.
Starting in January, some trees start putting out flowers—often very small flowers, but with copious pollen. And most of these early bloomers are pollinated by wind. The first one I notice around here is the tag alder or grey/hazel alder (Alnus serrulata)—this year in January. Cedar trees (Juniperus virginiana) put out cones (not flowers) soon after. Then other wind-pollinated species bloom, like winged elms (Ulmus alata), then others like wax myrtle (Morella cerifera), sweet gum (Liquidambar styraciflua), oaks (at least 10 species on campus, in the genus Quercus), hickories (in the genus Carya), and others. Longleaf pines (Pinus palustris), and later the more common loblolly pines (P. taeda) produce their male cones that cover everything with yellow-green dust. The large amount of pollen put into the air by wind-pollinated plants can cause allergies—my coughing and hacking is my body’s response to pollen blowing in the wind.
Flowering is all about sexual reproduction—pollen contains sperm, and must be moved by animals, wind, or water, preferably to another plant. While some plants can in fact pollinate themselves, pollinating a different plant increases genetic variation that might help them survive uncertainties and changeable environments. Insect pollination provides door-to-door delivery of pollen for many plants—this efficient means of pollen movement means that pollen is not traveling on the wind (so no allergies for us), and less pollen may be wasted. For example, another early bloomer, red maple (Acer rubrum), is insect pollinated. Yet insects are not always available or reliable. Wind-pollinated plants can do without insects, and can bloom early, when few insects are out. However, wind pollination is risky, because broadcasting pollen to the wind means taking a big chance that the wind will get the pollen to the right place—and it’s a guarantee that lots of pollen will land in the wrong place (it’s also a guarantee that lots of pollen will blow through the air, some into our lungs). One benefit of early flowering is that there are few obstructions (leaves) that might block pollen from getting to the right place. Thus, many wind pollinated trees bloom before leaves emerge. A few other things increase the chances of success for wind-pollinated plants: specialized, small male flowers hanging out in the wind, production of huge amounts of small pollen (carried more easily on the wind), specialized female flowers with sticky or feathery parts, like antennas to catch pollen, and timing it so that plants bloom at the same time.
Flowering synchrony (blooming at the same time) in trees is best known from oaks, which may benefit in several ways from this adaptation. Every few years or so, they go through something called “mast years” in which most of the oaks bloom at once—probably triggered by weather conditions (Bogdiewicz et al. 2020). First, it may make their wind pollination more efficient (Bogdziewicz et al. 2017). If everyone is blooming at once, there is a greater amount of pollen in the air from male flowers, and also a greater chance that female flowers will be out there to receive pollen. Second, it also helps their babies (acorns) survive better. Acorns have lots of predators (like blue jays mentioned last week). If oaks produce huge numbers at once, the predators can’t eat them all, so many seeds are more likely to make it through to germinate into new trees. Some studies suggest that acorn-eating beetles in a group called weevils (snout beetles) may reproduce so rapidly in mast years that they still eat the same percentage of acorns as in a normal year, or more (Bogdiewicz et al. 2018). Yet acorns may escape mammal predators like squirrels, mice, and deer during mast years (Greenberg and Zarnoch 2018).
There is a lot riding on the air… literally. And for a plant, there is a lot riding on pollen getting to the right place. There is a lot riding on it for us as well. Wind-pollinated species including oaks often make up the majority of trees in our forests, and they provide food, shelter, and habitat (hunting grounds, places to mate) for countless species. These forests are one of the most powerful forces counteracting global warming, by taking carbon-dioxide out of the atmosphere through photosynthesis.
We may not see these harbingers of spring—the flowers are small, and we have to be out looking for them early in the season. But we often notice them—our noses and our lungs notice them.
Many signs of spring are out now. I’ll discuss more in later posts. For now, I’ll go blow my nose…
References:
